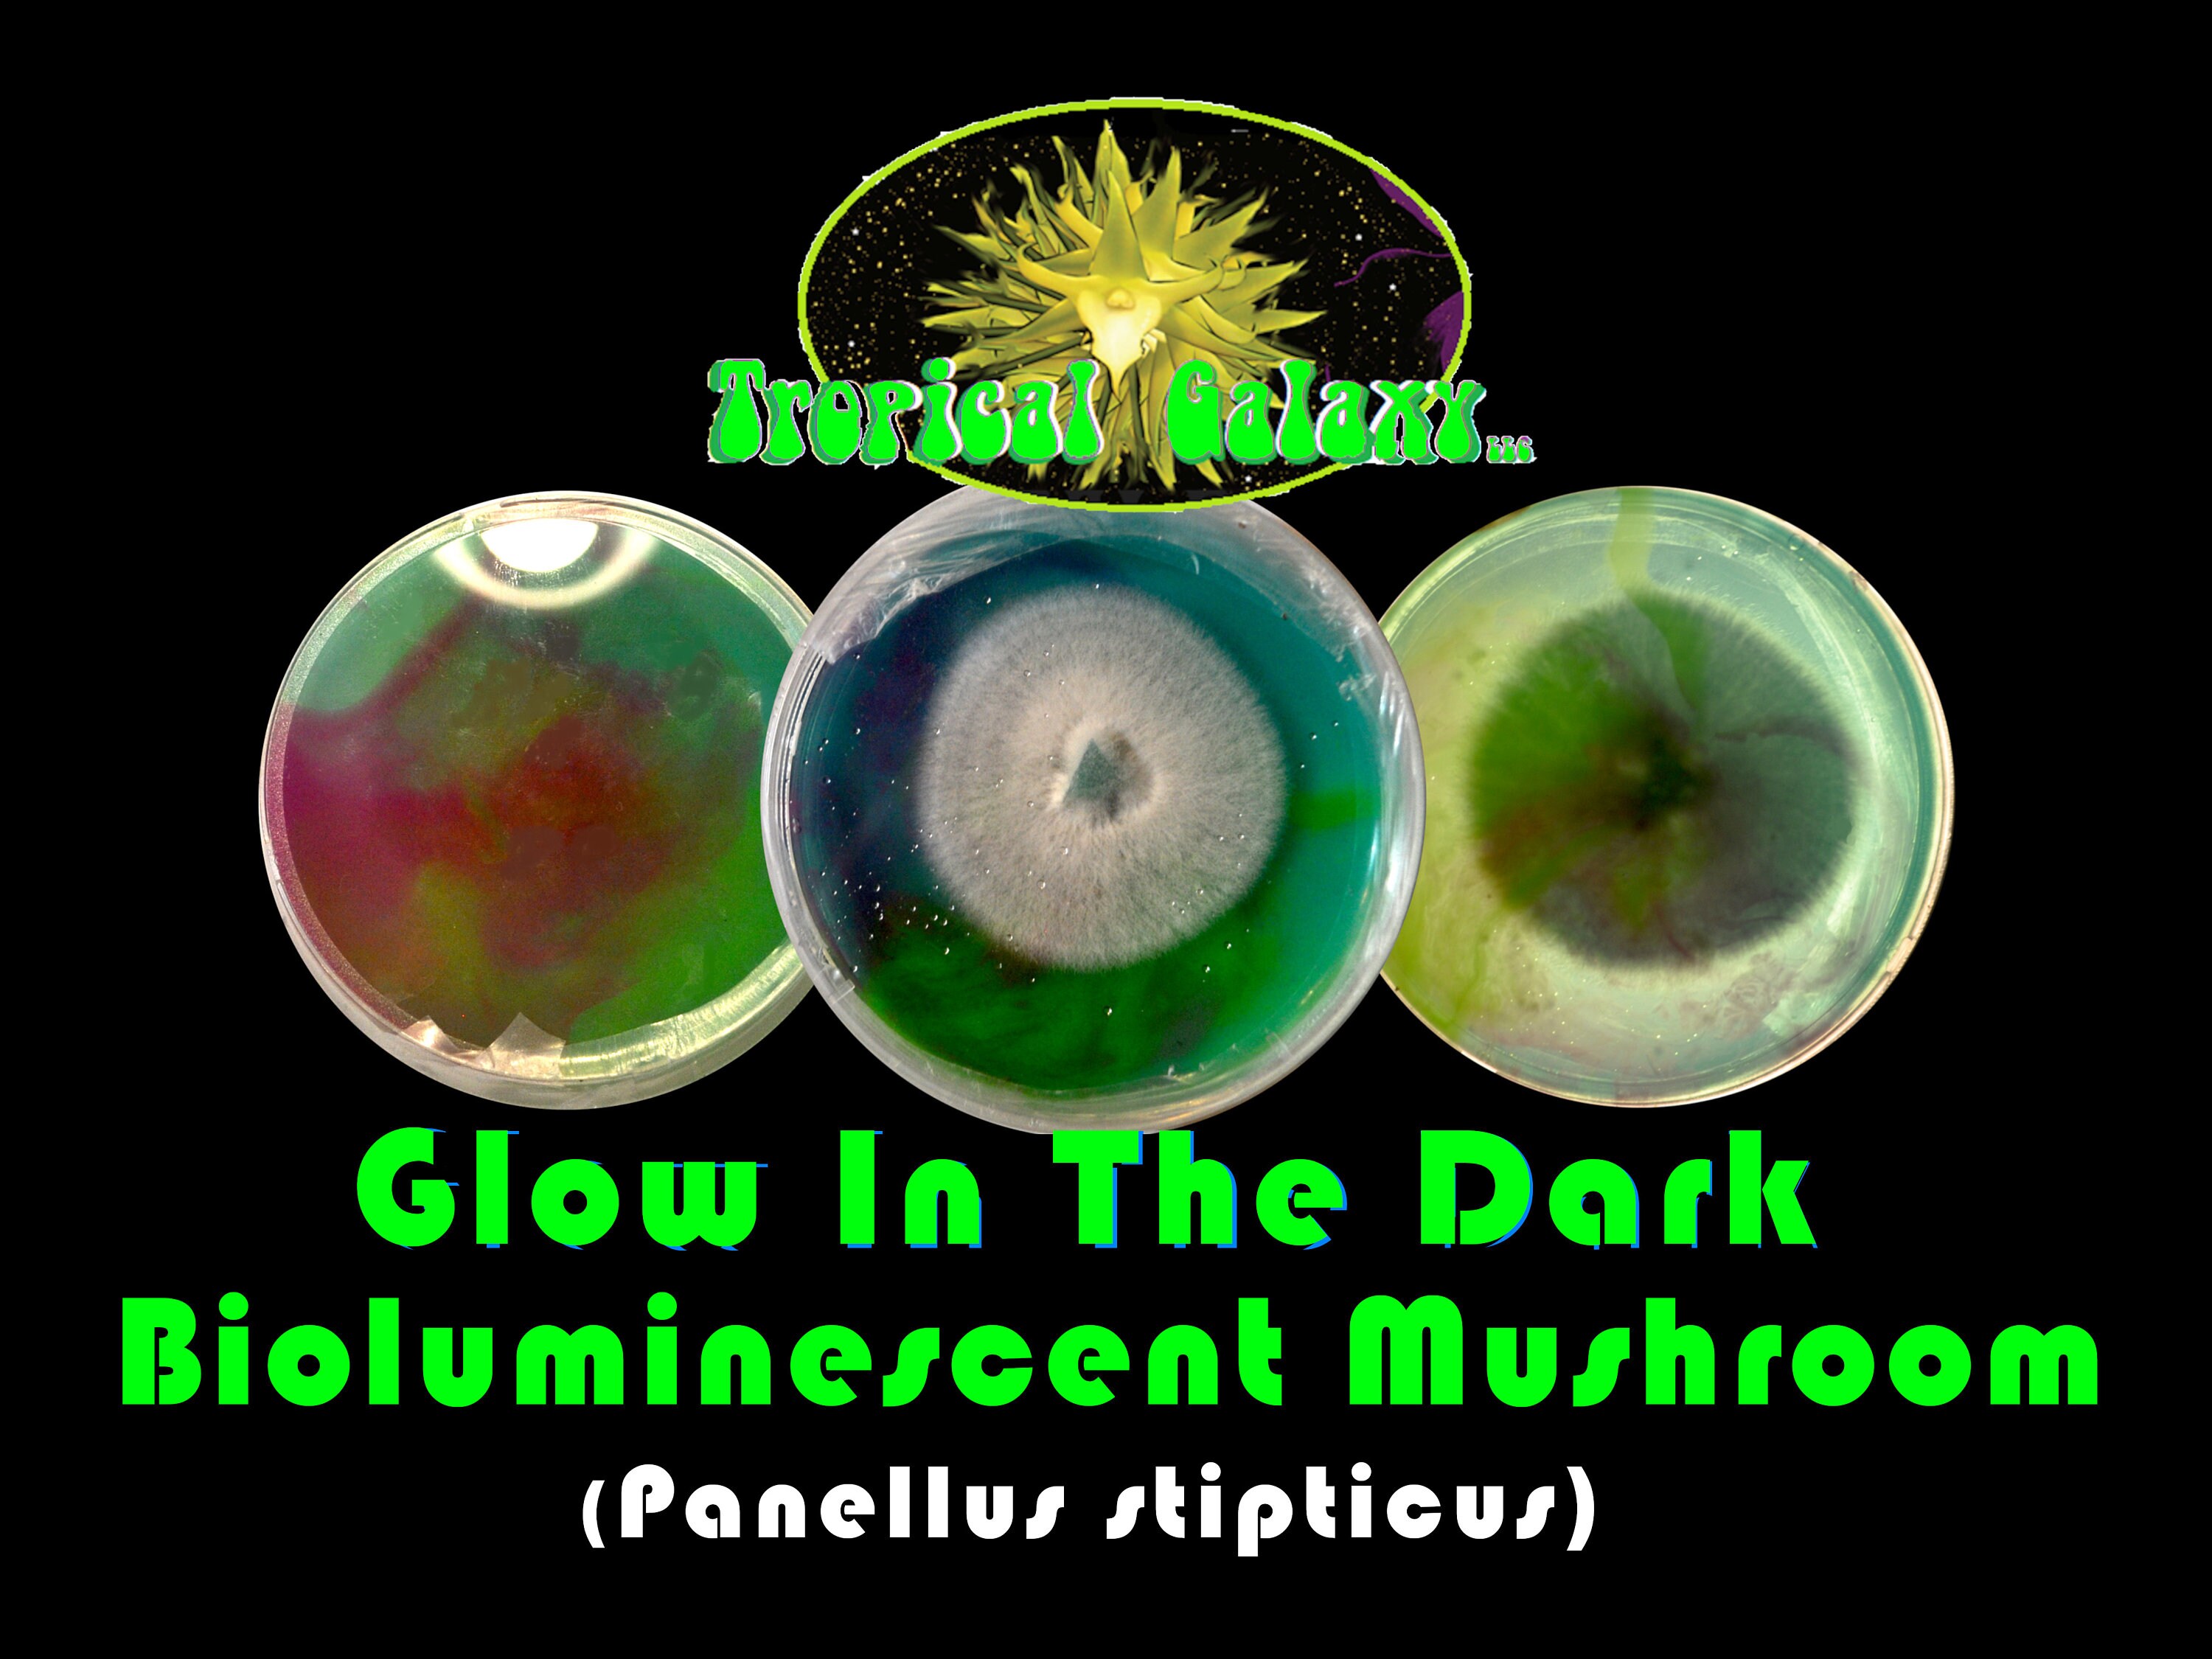

26+ Bioluminescent Plants For Sale

Bioluminescent Plant Etsy


Bioluminescent Plant Etsy

Glowing Plant Etsy Uk

Let There Be Light Nature Plants

Domthqmp8gchhm

Domthqmp8gchhm

Glowleaf Glow In The Dark Bioluminescent Plants For Sale

Scientists Create Glowing Flowers From The Dna Of Luminous Mushrooms

Glowing Plant Etsy Uk

Amazon Com Bioluminescent Plants

Artificial Bioluminescent Glow In The Dark Plants Aquarium Decorations Mk Aquarium Store

Artificial Bioluminescent Glow In The Dark Plants Aquarium Decorations Mk Aquarium Store

Glow In The Dark Plants And Other Bioluminescent Creatures Bbc Newsround

Iridescent Plants For Sale Flora Magnifica

Glowleaf Glow In The Dark Bioluminescent Plants For Sale
Bioluminescent Plant Etsy

Glowleaf Glow In The Dark Bioluminescent Plants For Sale

Glowleaf Glow In The Dark Bioluminescent Plants For Sale